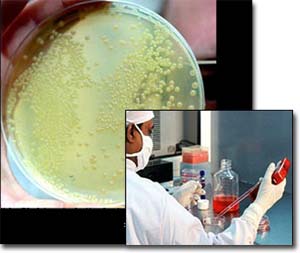

|
1 1
स्टेम
कोशिकाओं में छिपा मानव कल्याण
(कुछ संभावनाएं)
——डॉ. गुरुदयाल
प्रदीप
मस्तिष्क
तथा स्पाइनल कॉर्ड में रोग अथवा चोट के कारण घाव से ग्रसित
चूहों के रक्त में मानव अम्बेलिकल कॉर्ड के रक्त से
प्राप्त स्टेम कोशिकाओं को मिश्रित करने के बाद यह पाया
गया कि ये कोशिकाएँ ऐसे घावों तक पहुँच कर स्नायु तंत्र की
नई कोशिकाओं के निर्माण में सहायक हैं तथा इन रोग–ग्रसित
चूहों के स्वास्थ्य में कुछ सुधार हुआ है।
अजन्मे मानव–भ्रूण को सुरक्षा कवच प्रदान करने वाले
एम्नियॉटिक–द्रव से वैज्ञनिकों ने संभावना युक्त स्टेम
कोशिकाओं का पता लगाया है। रक्त से प्राप्त स्टेम सदृश्य
कोशिकाओं की सहायता से गंभीर हृदयाघात से पीड़ित चूहों के
जैविक क्रिया–कलापों के पुर्नस्थापना में वैज्ञानिकों ने
सफलता पाई है। स्टेम कोशिकाओं की सहायता से मस्क्युलर
डिस्ट्रॉफी नामक रोग से ग्रसित चूहों की क़मजोर पड़ती
मांसपेशियों को फिर से ठीक करने में वैज्ञानिकों को सफलता
मिली।
वैज्ञानिकों ने पता लगाया है कि उम्र के साथ घटती स्टेम
कोशिकाओं की संख्या हमारी धमनियों की मरम्मत में गतिरोध
उतपन्न करती हैं– जिसके कारण उनमें आर्थेरोस्क्लेरॉसिस
होने लगती है। फलत: धमनियों में रक्त के बहाव में बाधा
पड़ती है जो अंतत: हृदयाघात का कारण बन सकती है।
भ्रूणीय स्टेम कोशिकाओं के संबंध में चल रहे अनुसंधान के
फलस्वरूप वैज्ञानिकों को डायबिटीज़ के कारणों एवं निदान की
दिशा में कुछ नए सूत्र हाथ लगने की संभावना है।
चूहे की अस्थिमज्जा की स्टेम कोशिकाएँ अब स्नायुतंत्र की
कोशिकाओं में परिवर्तित की जा सकती हैं। वैज्ञानिकों ने
पहली बार स्टेम कोशिकाओं से फेफड़े के क्षतिग्रस्त ऊतकों की
पुनरोत्पत्ति में सफलता पाई। वैज्ञानिकों ने अब यह समझ
लिया है कि मुर्गी के भ्रूणीय विकास के दौरान कान के विकास
में संलग्न स्टेम कोशिकाओं को किस प्रकार नियंत्रित किया
जा सकता है।
ये चंद सुर्खियाँ हैं— विज्ञान जगत के उस हिस्से से जहाँ
वैज्ञानिक हम मनुष्यों के स्वास्थ्य के बारे में चिंतन
करते रहते हैं एवं अनुसंधान द्वारा इस बात के लिए
प्रयत्नशील रहतें हैं कि किस प्रकार जटिल से जटिल समस्याओं
का निदान सफलता पूर्वक किया जा सके तथा वर्तमान तकनीकि को
परिमार्जित कर हमारी स्वास्थ्य संबंधी समस्याओं को और
आसानी से सुलझाया जा सके।
उपरोक्त खबरें दे कर– केवल खबर देना ही इस आलेख का
उद्देश्य नहीं है बल्कि यहाँ इरादा है–इन खबरों के पीछे की
खबर लेना। अगर आप ध्यान से इन खबरों को पढ़ें तो आप पाएँगे
कि इन सब में स्टेम कोशिका एक ऐसा शब्द है जो सब जगह आया
है। तो आइए– सबसे पहले हम इसी बात की जाँच–पड़ताल कर लें कि
ये स्टेम कोशिकाएँ हैं क्या बला एवं वैज्ञानिक क्यों इनके
पीछे पड़े हुए हैं। बाद में इन खबरों और इन जैसी अन्य
महत्त्वपूर्ण खबरों की खबर भी ली जाएगी।
इन कोशिकाओं को स्टेम कोशिका का नाम जरूर दिया गया
है–परंतु पेड़ के तने से इनका दूर–दूर तक लेना–देना नहीं
हैं। ये कोशिकाएँ हमारे–आप के शरीर में–बल्कि यों कहें कि
उच्च श्रेणी के सभी जन्तुओं के शरीर में पाई जाती हैं।
भ्रूणीय विकास में इनकी भूमिका बड़ी ही महत्वपूर्ण है। इसके
साथ – साथ विकसित शरीर में भी विभिन्न प्रकार की कोशिकाओं
के उत्पादन के मूल में यही कोशिकाएँ होती है। इन कोशिकाओं
तथा इनके महत्व को समझने के लिए भ्रूणीय विकास की
प्रक्रिया का थोड़ा–बहुत ज्ञान आवश्यक है।
भ्रूणीय विकास का प्रारंभ शुक्राणु एवं डिंब के निषेचन से
निर्मित युग्मक की उत्पत्ति के साथ ही हो जाता है। युग्मक
तुरंत कोशिका विभाजन की प्रक्रिया में संलंग्न हो जाता है
और कुछ ही समय में सैकड़ों कोशिकाओं का उत्पादन होता है। इन
कोशिकाओं की संरचना तथा कार्यकी में कोई अंतर नही होता।
मानव भ्रूण में ये कोशिकाएँ ३ से ५ दिन के अंदर
पुनर्व्यवस्थित हो कर एक खोखले गेंद के आकार की
ब्लास्टोसिस्ट का निर्माण करती हैं। इस ब्लास्टोसिस्ट में
एक स्थान पर लगभग ३० से ३५ कोशिकाओं के एक गुच्छे का
निर्माण होता है– जिसे इनर सेल मास कहते हैं। इन कोशिकाओं
में भी कोई अंतर नहीं होता है। इन कोशिकाओं को स्टेम
कोशिका कहा जा सकता है क्यों कि अब इनके विभाजन के
फलस्वरूप सैकड़ों उच्च कोटि की विशिष्ट कोशिकाओं का उत्पादन
होता है–जिनकी संरचना एवं कार्यकी में अतंर होता है।
ये विशिष्ट कोशिकाएँ भ्रूणीय विकास के दौरान विभिन्न
प्रकार के ऊतकों के निर्माण में सहायक होती हैं। विकासशील
भ्रूण के विकसित हो रहे नाना प्रकार के ऊतकों में भी ये
स्टेम कोशिकाएँ पाई जाती हैं जो विभाजित हो कर तरह–तरह की
विशिष्ट ऊतकीय कोशिकाओं का निर्माण करती हैं, जिनका उपयोग
शरीर के विभिन्न अंगों यथा हृदय, फेफड़े, त्वचा आदि या फिर
अन्य प्रकार के ऊतकों के निर्माण में होता है।
यही नहीं, वयस्कों के विभिन्न अंगों जैसे अस्थिमज्जा,
मांसपेशी, मस्तिष्क एवं अन्य ऊतकों में भी ये स्टेम
कोशिकाएँ थोड़ी बहुत मात्रा में पाई जाती हैं। सामान्य
अवस्था में ये कोशिकाएँ निष्क्रिय पड़ी रहती हैं परंतु
बीमारी अथवा चोट या फिर समय के साथ जीर्णता के कारण जब इन
अंगों की ऊतकीय कोशिकाओं का ह्रास होने लगता है, तब ये
वयस्क स्टेम कोशिकाएँ हरकत में आती हैं एवं इस अंग विशेष
या ऊतक में प्रयुक्त विशिष्ट प्रकार की कोशिकाओं का
निर्माण कर क्षतिपूर्ति में सहायक होती हैं। क्यों कि
ऊतकीय कोशिकाएँ सामान्यत: कोशिका–विभाजन द्वारा अपने समान
नई कोशिकाओं के निर्माण में अक्षम होती हैं।
इन स्टेम कोशिकाओं में तीन विशिष्ट गुण समान रूप से पाए
जाते हैं – चाहे ये भ्रूणीय अवस्था की हों अथवा वयस्क शरीर
की।
-
पहली
बात तो यह कि इनकी संरचना एवं कार्यकी किसी भी साधारण
कोशिका के समान होती है। ये किसी भी ऊतक विशेष से मेल
नही खाते फलत: ऊतकीय कोशिकाओं के समान किसी विशिष्ट
कार्य यथा – लाल रूधिर कोशिकाओं के समान ऑक्सीजन ढोने
या फिर मांसपेशीय कोशिकाओं के समान शरीर की गतिशीलता
बनाए रखने जैसे कार्योंं में ये संलग्न नहीं हो सकतीं।
हाँ– आवश्यकता पड़ने पर कोशिका विभाजन द्वारा विशिष्ट
प्रकार की ऊतकीय कोशिकाओं को जन्म अवश्य दे सकती हैं।
-
दूसरी बात – ये स्टेम कोशिकाएँ सामान्य परिस्थितियों
में बार–बार कोशिका विभाजन की प्रक्रिया द्वारा अपने
ही समान नई कोशिकाओं के निर्माण की क्षमता रखती हैं।
इस प्रक्रिया को प्रॉलीफरेशन कहते हैं। प्रॉलीफरेशन से
प्राप्त नई कोशिकाएँ भी यदि किसी ऊतक–विशेष के गुणों
से युक्त न हो कर स्टेम कोशिकाओं के समान हों तो ऐसी
स्टेम कोशिकाओं को –लंबी अवधि तक स्व नवीनीकरण की
क्षमता से युक्त कहा जा सकता है।
-
तीसरी बात– आवश्यकता पड़ने पर, परिस्थिति विशेष में,
विभेदीकरण (डिफरेंशियेशन) द्वारा ये किसी ऊतक विशेष की
कोशिकाओं का निर्माण कर सकती हैं।
हमारे
शरीर की सभी कोशिकाएँ–चाहे वे स्टेम कोशिकाएँ हों अथवा
इनके विभेदीकरण से निर्मित ऊतकीय कोशिकाएँ हों–सभी का
प्रादुर्भाव निषेचित डिंब से होता है। फलत: इनकी जेनेटिक
संरचना में कोई अंतर नहीं होता। कोशिका की कार्यकी एवं
कार्य–कलापों को संचालित तथा नियंत्रित करने में इनमें पाए
जाने वाले जीन्स का हाथ होता है। ये जीन्स कोशिका की
आवश्यकतानुसार विशेष प्रोटीन्स के निर्माण में मुख्य
भूमिका निभाते हैं। ये प्रोटीन्स– कोशिका की संरचना में
प्रयुक्त होते हैं या फिर विभिन्न प्रकार के एन्ज़ाइम का
कार्य कर कोशिका की कार्यकी एवं क्रिया–कलापों के संचालन
में सहायक होते हैं। यहाँ ध्यान देने की बात यह है कि किसी
भी कोशिका में पाए जाने वाले सभी जीन्स एक साथ क्रियाशील
नहीं रहते। स्टेम कोशिकाओं तथा इनके प्रॉलीफरेशन से
उत्पन्न अविभेदित कोशिकाओं की संरचना एवं क्रियाकलापों के
नियमन के लिए इन कोशिकाओं में जीन्स का एक विशेष समूह
कार्यरत रहता है। जब ये कोशिकाएँ विभेदन द्वारा ऊतकीय
कोशिकाओं के उत्पादन में संलग्न होती हैं तब जीन्स के कुछ
नए समूह सक्रिय हो जाते हैं। अब तक सक्रिय जीन्स में से कई
निष्क्रिय हो जाते हैं। ये नए सक्रिय जीन्स ही नए
प्रोटीन्स का निर्माण कर स्टेम कोशिकाओं के विभेदीकरण का
नियंत्रण करते हैं एवं विभेदित हो रही कोशिकाओं की संरचना
तथा क्रिया–कलापों में अपेक्षित परिवर्तन कर ऊतक विशेष के
निर्माण में सहायक होते हैं।
आखिर वे
कौन सी परिस्थतियाँ एवं कारण हैं जो स्टेम कोशिकाओं में
जीन्स–विशेष के समूह को सक्रिय रख कर बिना विभेदित हुए
लगातार प्रॉलीफरेट कर अपने ही समान कोशिका निर्माण के लिए
उत्तरदाई हैं और फिर अचानक ऐसी कौन सी परिस्थतियाँ उत्पन्न
हो जाती हैं जो इन जीन्स मे से कई को निष्क्रिय कर देती
हैं तथा नए जीन्स–समूह को सक्रिय कर विभेदीकरण द्वारा
इन्हें किसी ऊतक–विशेष की कोशिका निर्माण के लिए प्रेरित
करती हैं। आज–कल वैज्ञानिकों तथा अनुसंधानकर्ताओं की
अभिरुचि स्टेम कोशिकाओं से संबंधित इन्हीं गुत्थियों को
सुलझाने में है। भविष्य में इनके विस्तृत अध्ययन से
प्राप्त ज्ञान के बल पर भ्रूणीय विकास की जटिलताओं को
अच्छी तरह समझा जा सकता है एवं जन्मजात बीमारियों से ले कर
क्षतिग्रस्त ऊतकों तथा अंगों की मरम्मत या फिर पूर के पूरे
अंग को ही प्रतिस्थापित किया जा सकता है।
वैज्ञानिक भ्रूणीय तथा वयस्क– दोनों ही प्रकार की स्टेम
कोशिकाओं के अध्ययन में लगे हुए हैं। इनके अध्ययन के लिए
इन्हें इनके स्रोत से अलग कर प्रयोगशाला में प्लास्टिक की
तश्तरियों में विशेष पोषक तत्वों से युक्त कल्चर माध्यम
में कृत्रिम रूप से कोशिका विभाजन के उत्प्रेरित किया जाता
है। इन तश्तरियों के भौतिक एवं रसायनिक पस्थितियों में
तरह–तरह के परिवर्तन कर यह जानने का प्रयास किया जाता है
कि किन परिस्थतियों में ये कोशिकाएँ बिना विभेदीकरण के
अपने ही समान कोशिकाओं के उत्पादन में संलग्न रहती हैं और
कब एवं किन परिस्थियों में विभेदीकरण की प्रक्रिया की ओर
उन्मुख हो कर किसी विशेष प्रकार की ऊतकीय कोशिका–उत्पादन
की प्रक्रिया में संलग्न हो जाती हैं।
वास्तव में यदि देखा जाय तो स्टेम कोशिकाओं–विशेषकर
अस्थिमज्जा में पाए जाने वाले विभिन्न प्रकार के रक्त
कोशिकाओं के उत्पादन में संलग्न वयस्क स्टेम कोशिकाओं से
संबंधित इतिहास लगभग ४० साल पुराना है। १९६० के दशक में ही
अनुसंधानकत्ताओं ने इस तथ्य की खोज कर ली थी कि अस्थिमज्जा
में दो प्रकार की स्टेम कोशिकाएँ पाई जाती हैं। एक तो
हिमैटोपॉइटिक स्टेम कोशिकाएँ–जो सभी प्रकार की रक्त
कोशिकाओं के उत्पादन में सक्षम होती हैं और दूसरी बोन मैरो
स्ट्रोमल कोशिकाओं का मिश्रित समूह, जिनसे
हड्डी–कार्टिलेज–वसा तथा फाइब्रर्स कनेक्टिव ऊतकों की
कोशिकाओं का उत्पादन होता है। पिछले ३० साल से इनका उपयोग
रक्त कैंसर से पीड़ित रोगियों के अस्थिमज्जा प्रतिस्थापना
में किया जा रहा है। १९६० के दशक में ही वैज्ञानिकों ने
चूहे के मस्तिष्क में दो ऐसे क्षेत्रों का पता लगा लिया
था– जहाँ वयस्क स्टेम कोशिकाएँ पाई जाती हैं तथा विभेदीकरण
कोशिका विभाजन द्वारा मस्तिष्क में पाए जाने वाले
स्नायुतंत्र की कोशिका–न्यूरॉन्स के साथ–साथ
ऑलिगोडेंड्राइड्स तथा एस्ट्रोसाइट्स के उत्पादन में भी
सक्षम हैं। इसके पूर्व वैज्ञानिकों का दृढ़ मत था कि वयस्क
मस्तिष्क में नई स्नायु कोशिकाओं का उत्पादन नहीं हो सकता।
भ्रूणीय स्टेम कोशिकाओं संबंधित अनुसंधान का इतिहास भी
कम से कम २० वर्ष पुराना है। परंतु मानव भ्रूण से संबंधित
अनुसंधान कार्य पिछले ४–५ वर्षों से ही हो रहे हैं।वर्षों
तक चूहों के भ्रूणीय स्टेम कोशिकाओं के विस्तृत अध्ययन के
पश्चात् १९९८ में ही हम यह समझ पाए है कि मानव भ्रूण से
स्टेम कोशिकाओं को किस प्रकार अलग किया जा सकता है एवं
उन्हें प्रयोगशाला में कृत्रिम रूप से कैसे संवर्धित
(कल्चर) किया जा सकता है।
मानव भ्रूणीय स्टेम कोशिकाएँ– डिम्ब के निषेचन के
पश्चात् ३ से ५ दिन तक विकास की प्रक्रिया पूरी कर
ब्लास्टोसिस्ट की अवस्था में पहुँचे भ्रूण की इनर सेल मास
से प्राप्त की जाती हैं। अनुसंधान के लिए स्त्री के
गर्भाशय में विकसित हो रहे भ्रूण को न लेकर उसके शरीर से
प्राप्त अनिषेचित डिंब को प्रयोगशाला में कृत्रिम रूप से
निषेचित कर कल्चर माध्यम में कोशिका विभाजन हेतु
अनुप्रेरित किया जाता है। जब ये भ्रूण ब्लास्टोसिस्ट की
अवस्था में पहँुच जाते हैं तब इनके इनर सेल मास की
कोशिकाओं को अलग कर ऐसी प्रयोगशालाओं को मुहय्या करा दिया
जाता है– जहाँ स्टेम कोशिका संबंधी अनुसंधान कार्य चल रहे
हों।
इन प्रयोगशालाओं में इनर मास की इन कोशिकाओं को समुचित
पोषक तत्वों से युक्त कल्चर माध्यम से भरी प्लास्टिक की
तश्तरियों मे स्थानांतरित कर दिया जाता है। इन तश्तरियों
के तले पर चूहे के भ्रूण से प्राप्त त्वचा की ऐसी
कोशिकाओें का लेप लगाया रहता है जो विभिन्न रसायनों से इस
प्रकार उपचारित (ट्रीटेड) रहती हैं कि इनमें कोशिका विभाजन
की क्षमता नहीं होती। कोशिकाओं का ऐसा लेप इन तश्तरियों
में स्थानांतरित इनर मास की कोशिकाओं के लिए गोंद का काम
करती हैं– जिससे ये आसानी से चिपक कर स्थिर हो जाती हैं।
इसके अतिरिक्त चूहे की कोशिकाओं का यह लेप कल्चर तश्तरी
में पोषक तत्वों का स्राव कर विभाजित हो रही इनर मास की
कोशिकाओं के लिए भोजन के स्रोत का कार्य करता है। हाल ही
में चूहे की ऐसी कोशिकाओं के लेप के बिना ही कल्चर तश्तरी
में इनर सेल मास की कोशिकाओं के प्रॉलीफरेशन की तकनीकि
विकसित कर ली गई है।
ऐसी तश्तरियों में इनर सेल मास की ये कोशिकाएँ कई
दिनों तक लगातार विभाजित होती रहती हैं। जब इनकी संख्या
पर्याप्त हो जाती है तो इन्हें बड़ी ही सावधानी तथा कोमलता
के साथ निकाल कर नई कल्चर तश्तरियों में एक तह के रूप में
स्थांतरित कर दिया जाता है। जब इन तश्तरियों में भी इनकी
संख्या आवश्यकता से अधिक होने लगती है तो इन्हें पुन: नई
तश्तरियों मे स्थानांतरित कर दिया जाता है। स्थानांतरण की
इस प्रक्रिया को लगातार कई महीने तक बार–बार दुहराया जाता
है जिसे 'सबकल्चरिंग' कहा जाता है। सबकल्चरिंग के एक चक्र
को 'पैसेज' का नाम दिया गया है।
लगभग छ: महीने या उससे भी लंबी अवधि तक सबकल्चरिंग के
फलस्वरूप इनर सेल मास की मूल कोशिकाओं से, जिनकी संख्या
मात्र ३० से ३५ होती है, लाखों भ्रूणीय कोशिकाओं का
उत्पादन होता है। चूँकि इनका उत्पादन बिना विभेदीकरण के
होता है, फलत: ये सभी कोशिकाएँ विभेदीकरण की क्षमता से
युक्त होती हैं एवं सभी प्रकार की ऊतकीय कोशिकाओं के
उत्पादन में सक्षम होती हैं। ऐसी क्षमता से युक्त इन
कोशिकाओं को 'एम्ब्रियॉनिक स्टेम सेल लाइन' के नाम से
पुकारा जाता है।
एक बार ऐसी सेल लाइन की स्थापना के बाद इन कोशिकाओं को
अति कम तापमान पर फ्रीज कर अन्य प्रयोगशालाओं में भेजा जा
सकता है–जहाँ इनका आगे भी कल्चर किया जा सकता है या फिर
इन्हें तरह–तरह के अभिनव प्रयोगों में प्रयुक्त कर इनके
विभेदीकरण की क्षमता को परखा जा सकता है तथा किन
परिस्थितियों में इनसे किस ऊतक विशेष की कोशिकाओं का
ऊत्पादन हो रहा है–इस तथ्य का ज्ञान भी प्राप्त किया जा
सकता है।
इन भ्रूणीय कोशिकाओं को जब तक विशिष्ट परिस्थितियों
में कल्चर किया जाता है तब तक ये बिना विभेदीकरण के अपने
ही समान अविभेदित कोशिकाओं का उत्पादन करती रहती हैं–परंतु
जैसे ही इन्हें एक साथ एक पिंड के रूप में विकसित हो कर
एम्ब्रॉयड बॉडी बनाने का अवसर मिलता है ये कोशिकाएँ
विभेदीकरण की प्रक्रिया में स्वत: जुट जाती हैं तथा
विभिन्न प्रकार के ऊतकीय कोशिकाओं यथा— मांसपेशी,
स्नायुतंत्र आदि की कोशिकाओं का उत्पादन कर सकती है।
हालाँकि इस प्रकार की स्वत: विभेदीकरण की प्रक्रिया कल्चर
तश्तरियों में विकसित हो रहे स्टेम कोशिकाओं के अच्छे
स्वास्थ्य का द्योतक अवश्य हैं– परंतु यह किसी ऊतक विशेष
की विशिष्ट कोशिकाओं के उत्पादन का प्रभावकारी तरीका नहीं
है।
किसी ऊतक
विशेष की विशिष्ट कोशिका के उत्पादन के लिए वैज्ञानिक इन
कल्चर तश्तरियों में विकसित हो रहे 'स्टेम सेल लाइन' की
कोशिकाओं के विभेदीकरण की प्रक्रिया को, कल्चर माध्यम के
रासायनिक संयोजन में या फिर कल्चर माध्यम की सतह में
परिवर्तन कर, प्रभावित करते हैं। इसके अतिरिक्त वे इन
कोशिकाओं में नए जीन्स को समावेशित कर स्टेम लाइन की
कोशिकाओं को ही संशोधित करने का प्रयास करते हैं।
उदाहरण के लिए यदि हमें डोपामाइन तथा सिरेटोनिन जैसे
रसायन का स्राव करने वाली स्नायुतंत्र की कोशिकाओं का
उत्पादन करना हो या फिर इन्सुलिन का स्राव करने वाले
पैंक्रियाटिक आइलेट्स की कोशिकाओं का– तो सबसे पहले
एम्ब्रॉयड बॉडी को आई टी एफ एसएन (इनसुलिन ट्रान्सफॉमिन
फाइब्रोनेक्टिन सेलेनियम) से युक्त कल्चर माध्यम में रखा
जाता है। फिर इनमें से नेस्टिन पॉजिटिव कोशिकाओं को चुनकर
नाइट्रोजन तथा एसिडिक फाइब्रोब्लास्ट ग्रोथ फैक्टर से
युक्त दो विभिन्न कल्चर माध्यम में स्थानांतरित कर दिया
जाता है। इसमें से एक कल्चर माध्यम में अतिरिक्त रसायन के
रूप में लैमिनिन एवं दूसरे में बी २७ मीडिया सप्लिमेंट
होता है। लैमिनिन युक्त कल्चर माध्यम की कोशिकाएँ –नेस्टिन
पॉजिटिव न्यूरल प्रिकर्सर कोशिकाओं– में विभेदित होने लगती
हैं तो बी २७ मीडिया सप्लिमेंट युक्त माध्यम की केशिकाएँ
–नेस्टिन पॉजिटिव पैंक्रियाटिक प्रोजीनेटर कोशिकाओं– में।
जब न्यूरल प्रिकर्सर कोशिकाओं के कल्चर से एसिडिक
फाइब्रोब्लास्ट ग्रोथ फैक्टर को हटा दिया जाता है तो ये
कोशिकाएँ डोपामाइन तथा सिरेटोनिन का स्राव करने वाली
स्नायु कोशिकाओं मे विभेदित होने लगती हैं–वहीं जब
पैंक्रियाटिक प्रोजिनेटर कोशिकाओं के कल्चर से इन्हीं
विशिष्ट ग्रोथ फैक्टर को हटा कर निकोटिनेमाइड नामक पोषक
तत्व का समावेश किया जाता है तो ये इन्सुलिन का स्राव करने
वाले पैंक्रियाटिक आइलेट्स की कोशिकाओं के गुच्छे में
विभेदित होने लगती हैं।
यदि वैज्ञानिक इसी प्रकार मानव भ्रूण की स्टेम
कोशिकाओं के विभेदन द्वारा सभी प्रकार के विशिष्ट ऊतकीय
कोशिकाओं के उत्पादन की प्रक्रिया को सुचारु एवं सुनिश्चित
रूप से नियंत्रित कर सकने में सक्षम हो जाएँ, तो भविष्य
में ऊतक विशेष की इस प्रक्रिया द्वारा उत्पन्न कोशिकाओं का
प्रत्यारोपण कर नाना प्रकार के रोगों तथा व्याधियों पर
आसानी से विजय पाई जा सकती है। पर्किन्सन रोग (शरीर के
अनियंत्रित कंपन तथा अकड़न उत्पन्न करने के साथ–साथ
गतिशीलता को कम करने वाला रोग), डायबिटिज, इस्पाइनल कॉर्ड
में क्षतिग्रस्त स्नायु कोशिकाओं के कारण उत्पन्न मानसिक
रोग, डचेन्स मस्क्युलर डिस्ट्रॉफी (एक विशेष प्रकार की
मांसपेशीय क्षीणता का रोग) नाना प्रकार के हृदय रोग तथा
देखने एवं सुनने की क्षमता का उम्र के साथ ह्रास होने जैसे
तमाम रोग इस संभावना के क्षेत्र में आते हैं।
भविष्य में पर्किन्सन रोग के निदान में सबसे पहले
सफलता मिलने की संभावना है। यह रोग २ प्रतिशत लोगों में
उम्र के साथ डोपामाइन नामक रसायन का स्राव करने वाले
विशिष्ट स्नायु कोशिकाओं के क्षय से संबंधित है। जैसा कि
आप ने ऊपर पढ़ा, प्रयोशालाओं में भ्रूणीय कोशिकाओं से
डोपामाइन का स्राव करने वाली स्नायु कोशिकाओं के उत्पादन
की सफल तकनीकि विकसित कर ली गई है। इस प्रकार उत्पादित
कोशिकाओं का ऐसे रोगियों में प्रत्यारोपण कर– संभवत: इस
रोग से छुटकारा पाया जा सकता है।
यह तो मात्र एक उदाहरण है। इस आलेख के प्रारंभ में
झल्कियों के रूप में दिए गए समाचारों की कुछ सुर्खियाँ– इस
दिशा में किए जा रहे अनुसंधानों में मिल रही सफलताओं को
दर्शा रही हैं। भविष्य के गर्भ में इस प्रकार के
अनुसंधानों में अनंत संभावनाएँ छिपी हुई हैं, जो रोग–निदान
के क्षेत्र में क्रान्तिकारी परिवर्तन ला सकती हैं।
यही नहीं– प्रयोगशालाओं में स्टेम कोशिकाओं द्वारा
उत्पादित विभिन्न प्रकार के ऊतकीय कोशिकाओं का उपयोग नई–नई
औषधियों का प्रभाव परखने के लिए भी किया जा सकता है, जिसके
फलस्वरूप किसी रोग विशेष से ग्रसित रोगियों या फिर अन्य
जन्तुओं का गिनी पिग की तरह उपयोग करने से बचा जा सकता है।
साथ ही अधिक विश्वसनीय परिणाम भी प्राप्त किए जा सकते हैं।
वयस्क स्टेम कोशिकाओं को ले कर किए जा रहे अनुसंधान भी
इसी दिशा की महत्वपूर्ण कड़ियाँ हैं। वैसे तो वयस्क स्टेम
कोशिकाओं की पहचान शरीर के कई अंगों एवं ऊतकों यथा
मस्तिष्क, अस्थि, मज्जा, रक्त, रक्त वाहिनियों, अस्थि–पंजर
से जुड़ी मांस पेशियों, त्वचा तथा यकृत आदि में की जा चुकी
है। फिर भी वास्तव में ये कितने प्रकार के होते हैं तथा और
कहाँ–कहाँ स्थित हैं, इस बारे में सही एवं सुनिश्चित
जानकारी अभी भी नहीं है। इन कोशिकाओं के बारे में एक और
महत्वपूर्ण बात यह है कि किसी भी वयस्क अंग या ऊतक में ये
बहुत ही थोड़ी मात्रा में मिलती हैं तथा वर्षों तक बिना
कोशिका विभाजन के सुसुप्तावस्था में पड़ी रह सकती हैं। किसी
बीमारी या ऊतकों में चोट के फलस्वरूप सक्रिय हो कर ये उस
अंग या ऊतक से संबंधित कोशिकाओं के उत्पादन में संलंग्न हो
जाती है।
अस्थिमज्जा तथा मस्तिष्क में पाए जाने वाली स्टेम
कोशिकाओं के विभेदीकरण के फलस्वरूप उत्पादित ऊतकीय
कोशिकाओं के बारे में पहले ही बताया जा चुका है। इसके
अतिरिक्त आहार नाल की इपीथीलियल स्टेम कोशिकाएँ–
एबजॉर्टिव–गॉब्लेट–पैनेथ एवं एन्टेरोएन्डोक्रीन जैसी
कोशिकाओं के उत्पादन में सक्षम होती हैं। इसी प्रकार त्वचा
के इपीडर्मिस की बेसल स्तर तथा हेयर फॉल्किल के आधार में
पाए जाने वाली स्टेम कोशिकाएँ क्रमश: किरैटिनोसाइट तथा नए
हेयर फॉलिकिल एवं इपीडर्मिस की कोशिकाओं के उत्पादन में
सक्षम होती हैं।
अब तक यह सोचा जाता था कि वयस्क स्टेम कोशिकाएँ उसी
अंग या ऊतक की कोशिकाओं का उत्पादन करने में सक्षम होती
हैं जहाँ वे पाई जाती हैं। लेकिन हाल के प्रयोगों से यह
पता चला है कि एक अंग अथवा ऊतक में पाए जाने वाली कुछ
विशेष प्रकार की वयस्क स्टेम कोशिकाएँ विशेष परिस्थितियों
में अन्य अंगों एवं ऊतकों की कोशिकाओं का उत्पादन भी कर
सकती हैं। इन स्टेम कोशिकाओं की इस विशिष्ट क्षमता को
–प्लास्टिसिटी– अथवा –ट्रांसडिफरेन्शियशन– की संज्ञा दी गई
है। प्रस्तुत हैं ऐसे ही कुछ उदाहरण:
हिमैटोपॉयटिक स्टेम कोशिकाओं से स्नायु तंत्र की
न्यूरॉन–ऑलिगोडेन्ड्राइड्स तथा एस्ट्रोसाइट्स जैसी
कोशिकाओं से ले कर अस्थि पंजर एवं हृदय की मांसपेशियों तथा
यकृति की कोशिकाओं का उत्पादन किया जा सकता है। इसी
प्रकार– अस्थि मज्जा की स्ट्रोमल कोशिकाओं से भी अस्थि
पंजर तथा हृदय की मांसपेशियों का उत्पादन संभव है और
मस्तिष्क की स्टेम कोशिकाओं का उपयोग रक्त में पाई जाने
वाली विभिन्न कोशिकाओं तथा अस्थि पंजर की मांसपेशीय
कोशिकाओं के विकास में किया जा सकता है।
सीमित विभेदीकरण की क्षमता के बावजूद वयस्क स्टेम
कोशिकाओं का प्रत्यारोपण की प्रक्रिया में उपयोग करने का
सबसे महत्वपूर्ण लाभ यह होगा कि वयस्क रोगी के शरीर से ही
इन स्टेम कोशिकाओं को निकाल कर, इच्छित ऊतकीय कोशिकाओं का
उत्पादन कर, उसी रोगी के शरीर में प्रत्यारोपित किया जा
सकेगा। इस प्रकार प्रत्यापित कोशिकाएँ रोगी के शरीर के
प्रतिरोधी तंत्र द्वारा अस्वीकृत भी नही होंगी। जब कि
भ्रूणीय स्टेम कोशिकाओं से प्राप्त उतकीय कोशिकाओं का रोगी
के शरीर के प्रतिरोधी तंत्र द्वारा अस्वीकृत कर दिए जाने
का खतरा सदैव बना रहेगा, जिससे निपटने के लिए
प्रतिरोध–उन्मूलक औषधियों का सहारा लेना पड़ेगा।
स्टेम कोशिकाओं से संबंधित अनुसंधान कार्य अभी
नवजात अवस्था में ही है तथा इनके बारे में हमारा ज्ञान
अधूरा है। अभी भी बहुत से प्रश्नों के उत्तर मिलने शेष
हैं। जैसे–जैसे इस क्षेत्र में नई–नई खोंजे हो रही हैं
वैसे–वैसे कुछ नए अनुत्तरित प्रश्न भी वैज्ञानिको के समक्ष
चुनौती बन कर प्रस्तुत होते जा रहे हैं। इन नए–नए प्रश्नों
के उत्तर खोजने तथा इनमें छिपी मानव स्वास्थ्य कल्याण की
अनन्त संभावनाओं के कारण आजकल वैज्ञानिक जगत में ऐसे
अनुसंधानों के प्रति अतिरिक्त उत्साह एवं सक्रियता है। आशा
है– निकट भविष्य में ही इनके अथक परिश्रम के फल से संपूर्ण
मानव समाज लाभान्वित होगा।
|